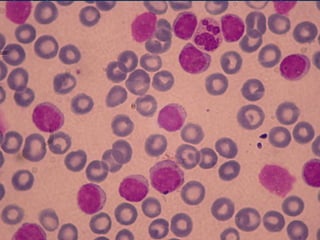

Ce document présente l'interprétation de l'hémogramme, qui est un examen sanguin essentiel permettant d'analyser les différents éléments figurés du sang, tels que les globules rouges, les globules blancs et les plaquettes. Il décrit les techniques de prélèvement, d'analyse, les anomalies possibles, ainsi que des cas cliniques illustrant diverses pathologies. L'hémogramme est essentiel pour le diagnostic de conditions telles que l'anémie, la leucémie et les troubles plaquettaires.